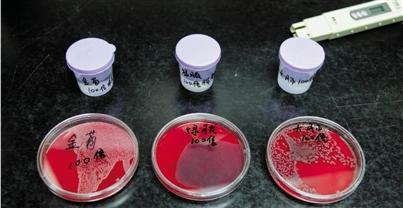

致病菌超标还说能喝 网上热卖“水质笔”不靠谱
参与互动(0)“买一支TDS水质检测笔,一测就能知道家里的水质到底是好是坏。”最近,一种售价从几十元到几百元不等,名为TDS笔的水质检测仪器在网上销售火爆。
尽管卖家一个个拍着胸脯说这支个头比记号笔大一点的TDS水质检测笔“很灵”,但也有网友吐槽说,TDS水质检测笔“不靠谱”,不仅不能准确反映水质,甚至明明细菌超标的水,检测笔仍然显示水质优良。
真相究竟怎样,TDS水质检测笔到底能不能检测出水质好坏?钱江晚报记者也在淘宝上买了一支TDS水质检测笔,并联合浙江大学医学院附属第二医院(以下简称“浙医二院”)检验科,对TDS水质监测笔的测试效果进行实验。最终的检测结果显示:即便是含有大肠杆菌、金黄葡萄球菌等致病菌的水,用TDS水质检测笔检测仍属“理想饮用水”——这样的检测笔你可千万不能相信啊!
实验样本
“纯不纯净,一测便知”、“进口芯片,安全更放心”……在淘宝网上搜索水质检测笔,立马跳出3000多种商品,价格从10多元到700多元不等,无一例外的是卖家们都异口同声地标榜这种水质检测笔:使用简便而且结果准确。
卖得最好的是价位在60~100元区间内的水质检测笔,在网络上销量排行第一位的某店家月销量达到1500多件。钱江晚报记者随即在该店家购买了一款卖得最火的60元左右的水质检测笔,送到浙医二院检验科细菌室,进行关于TDS水质检测笔水质检测效果的实验。
实验说明
根据使用说明,当TDS水质检测笔置于被检测水样中:检测笔数值显示为“0~50”区间内时,是“理想饮用水”;数值显示“50~100”区间内时,是“矿泉水”;数值显示“100~200”是“硬水”,数值显示“200~300”区间时,是“勉强可以接受的自来水”;数值显示“300~400”区间时,是“较差状态”的水;数值显示“500以上”区域时,是“U.S.EPA(美国环境保护署)规定最大污染物的水平”。
实验操作
浙医二院检验科医生朱志强
实验过程

第一步:分别选取纯水、0.45%盐水、自来水和白开水4种水,将水质检测笔分别置于水样中,检测出的TDS值分别是0、294、85、85。与水质检测笔的说明书对照,水质优劣排序依次为纯水、自来水=白开水、0.45%盐水。这也是多数商家在网店中所做的实验图示,看上去似乎符合其说明书的解释。
第二步:用实验室高压后的纯净水,即TDS数值显示为0的“理想饮用水”为基础,分别加入大肠埃希菌、铜绿假单细胞菌、金黄色葡萄球菌,这三种常见的致病细菌再次进行实验。同时,设计了分别加入原始浓度为0.5McF(相当于每毫升水中含有的微生物群落总数为1.5×10的8次方)的原倍、10倍稀释和100倍稀释等不同情况的水样。
实验结果
插入这些水样中的TDS水质检测笔,会报告出什么样的数值呢?
根据实验结果,在高压后纯净水中加入原倍、10倍稀释和100倍稀释等不同情况下:大肠埃希菌水样中TDS水质检测笔显示数值分别为7、1、1;金黄葡萄球菌的数值分别为5、1、1;铜绿假单细胞的数值分别是7、2、1。
对照水质检测笔使用说明,我们可以知道,即使是加入了不同程度的致病细菌,若根据TDS检测的数值来看,水质检测笔仍然认为这些水还属于“理想饮用水”。
“实验结果显示,十倍稀释之后的细菌加入到纯水后检测数值,几乎与纯水中的数值没有什么区别,但是这样数量级的细菌已具有非常强的致病性。”负责实验的朱志强医生解释说,根据国家标准GB5749-2006《生活饮用水卫生标准》,对于生活饮用水的检测包括微生物指标、毒理指标、感官性状和一般化学指标、放射性指标等几大类,多达106项指标,而所谓的“TDS”水质检测笔其实只能测试溶解质固体,仅是反应水质的一个宽泛的指标,无法反应水质中的其他指标。单纯以这类检测笔的数值为依据,显然无法全面反映水质。
水并非越纯越好
浙江工商大学环境科学与工程学院教授、博士生导师沈东升:
以总溶解性固体作为指标去衡量水质,这样的水质检测笔显然是在偷换概念,忽悠消费者。
水质检测指标数量很多,至少需要10多台专业仪器设备才能分析出来,而这些专业仪器的身价有不少达到几十万元甚至上百万元。靠一支几十元或数百元的所谓水质检测笔100%不靠谱。
即便在水质中不含致病菌等因素下,水质检测笔的数值区间对于水质的理解也是片面、不科学的。TDS值不能准确反映水质,不能说TDS数值200的水比300的水质要好。因为一方面水中一些人体需要的矿物质也会被TDS检测出来,另一方面水中对人体有害的大肠杆菌等菌类,却无法被TDS检测到。
按照其标准,水质排序应该为纯净水、矿泉水、矿物质水、自来水。事实上,水并非越纯越好,纯净水通过对自来水进行特殊工艺的深加工,去掉了水中的一些有害物质,因而更加“干净”。但纯净水在过滤和反渗透的过程中,会损失掉水中许多有益的矿物质和微量元素。
>能源频道精选:




















